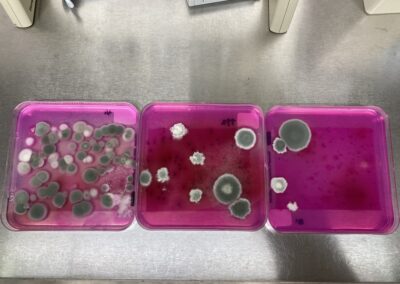

Étude SporeWatch France
Une étude à l’échelle nationale
Aspergillus fumigatus, champignon microscopique, présent dans l’air que nous respirons, est généralement inoffensif. Mais il peut provoquer des infections graves, parfois mortelles (aspergillose invasive) chez les patients immunodéprimés notamment. Et un phénomène inquiétant s’amplifie depuis 25 ans : les médicaments antifongiques azolés, traitements de référence, perdent de leur efficacité. Pourquoi ? Parce que les molécules de cette famille sont massivement utilisées comme fongicides dans les champs et pour protéger les matériaux. Ce double usage médical et environnemental favorise l’émergence de souches résistantes dans l’environnement. Résultat : le risque d’échec thérapeutique augmente, compromettant la survie des patients les plus vulnérables. Afin d’obtenir des données de surveillance fiables, il est urgent de mettre en place des systèmes mesurant cette aérocontamination.
L’installation en extérieur (jardin, balcons…), de capteurs développés par les Pays-Bas, permettra d’étudier la prévalence aéroportée des Aspergillus fumigatus résistants aux antifongiques et d’évaluer le risque d’exposition à ces souches résistantes.
SporeWatchFrance est un volet du projet international GAP-AFR (porté par Eveline Snelders aux Pays-Bas)
Chronologie de l’étude
28 juillet 2025
Lancement du questionnaire en ligne pour la recherche de volontaires
15 septembre 2025
Fin des inclusions des participants
25 septembre 2025
Envois des mails aux volontaires sélectionnés
2-3 octobre 2025
Préparation des kits de prélèvements
9 octobre 2025
Envoi des colis
15 octobre 2025
Dépôts des deltatraps – collecte des échantillons sur 6 semaines
décembre 2025
Renvoi des échantillons par les participants
janvier – avril 2026
Analyses des échantillons qui seront conformes (deltatraps installés pendant 6 semaines et renvoyés dans les conditions préconisées). Protocole d’analyse sur 2 semaines (60 deltatraps analysés par semaine).
mai 2026
Premiers résultats sur la prévalence de la résistance au niveau national
juin – septembre 2026
Analyses des mécanismes conférant la résistance et analyses spatiales des données (en lien avec le climat, l’occupation des terres)
Suivez l’actualité de l’étude sur le LinkedIn du laboratoire Chrono-environnement !
#sporewatchfrance
Analyses des deltatraps
L’équipe SporeWatchFrance analyse les deltatraps reçus : Vérification de la conformité d’échantillonnage (période et informations renseignées), saisies des données, fabrication des trois milieux de culture, mise en culture, comptage des colonies, conservation des colonies fongiques pour analyses ultérieur.
Pour chaque série d’échantillon, c’est un protocole de 15 jours qui est réalisé.